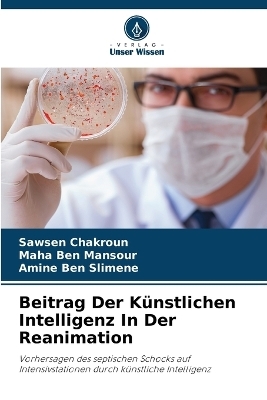
Beitrag Der K&uuml;nstlichen Intelligenz In Der Reanimation - Sawsen Chakroun, Maha Ben Mansour, Amine Ben Slimene

Beitrag Der Künstlichen Intelligenz In Der Reanimation
Seiten
2025
Verlag Unser Wissen
978-620-8-69554-5 (ISBN)
Verlag Unser Wissen
978-620-8-69554-5 (ISBN)
- Titel nicht im Sortiment
- Artikel merken
Die Früherkennung eines septischen Schocks ist entscheidend für die Verbesserung der Patientenergebnisse. Ziel dieser Studie ist die Entwicklung eines Modells für maschinelles Lernen, das XGBoost verwendet, um einen septischen Schock sechs Stunden im Voraus vorherzusagen. Das Modell wurde mit einem öffentlichen Datensatz trainiert, der 40.336 Patienten umfasste. Es wurde an einem Teil dieses Datensatzes getestet und erreichte eine Genauigkeit von 0,97 und eine AUC von 0,874. Es wurden auch Vorhersagen für 8, 10 und 12 Stunden im Voraus gemacht, die eine Genauigkeit von 0,899, 0,891 und 0,8954 und AUCs von 0,867, 0,8639 und 0,8530 ergaben. Außerdem wurde das Modell an einem lokalen Datensatz des Fattouma Bourguiba Universitätskrankenhauses getestet, der 30 Patienten umfasste. Für die 6-Stunden-Vorhersage im lokalen Datensatz erreichte das Modell eine Genauigkeit von 0,89 und eine AUC von 0,74. Die Vorhersagen für 8, 10 und 12 Stunden im Voraus zeigten eine Genauigkeit von 0,8861, 0,8772 und 0,8718 und AUCs von 0,73, 0,72 bzw. 0,72. Das XGBoost-Modell zeigt ein Potenzial für die Früherkennung des septischen Schocks, bedarf aber für die klinische Anwendung weiterer Tests und Optimierungen.
Prof. Sawsen Chakroun - Leiter der Abteilung für pädiatrische Anästhesie und Intensivmedizin am Centre Hospitalo Universitaire in Monastir, Tunesien.Professeur Agrégé en Anesthésie Réanimation (außerordentlicher Professor für Anästhesie und Reanimation).
| Erscheinungsdatum | 05.03.2025 |
|---|---|
| Sprache | deutsch |
| Maße | 152 x 229 mm |
| Gewicht | 86 g |
| Themenwelt | Medizin / Pharmazie ► Allgemeines / Lexika |
| Medizin / Pharmazie ► Gesundheitsfachberufe | |
| Schlagworte | Früherkennung • Gesundheit. • Künstliche Intelligenz • machine learning • Septischer Schock • xgboost |
| ISBN-10 | 620-8-69554-6 / 6208695546 |
| ISBN-13 | 978-620-8-69554-5 / 9786208695545 |
| Zustand | Neuware |
| Informationen gemäß Produktsicherheitsverordnung (GPSR) | |
| Haben Sie eine Frage zum Produkt? |
Mehr entdecken
aus dem Bereich
aus dem Bereich
Das Standardwerk für die regelkonforme Verordnung von Heilmitteln
Buch (2024)
Intellimed (Verlag)
CHF 34,95
medizinischer Grundwortschatz und Fachwörterlexikon für Pflegeberufe
Buch | Softcover (2022)
Börm Bruckmeier Verlag
CHF 26,60
Buch | Softcover (2025)
Urban & Fischer in Elsevier (Verlag)
CHF 55,95


